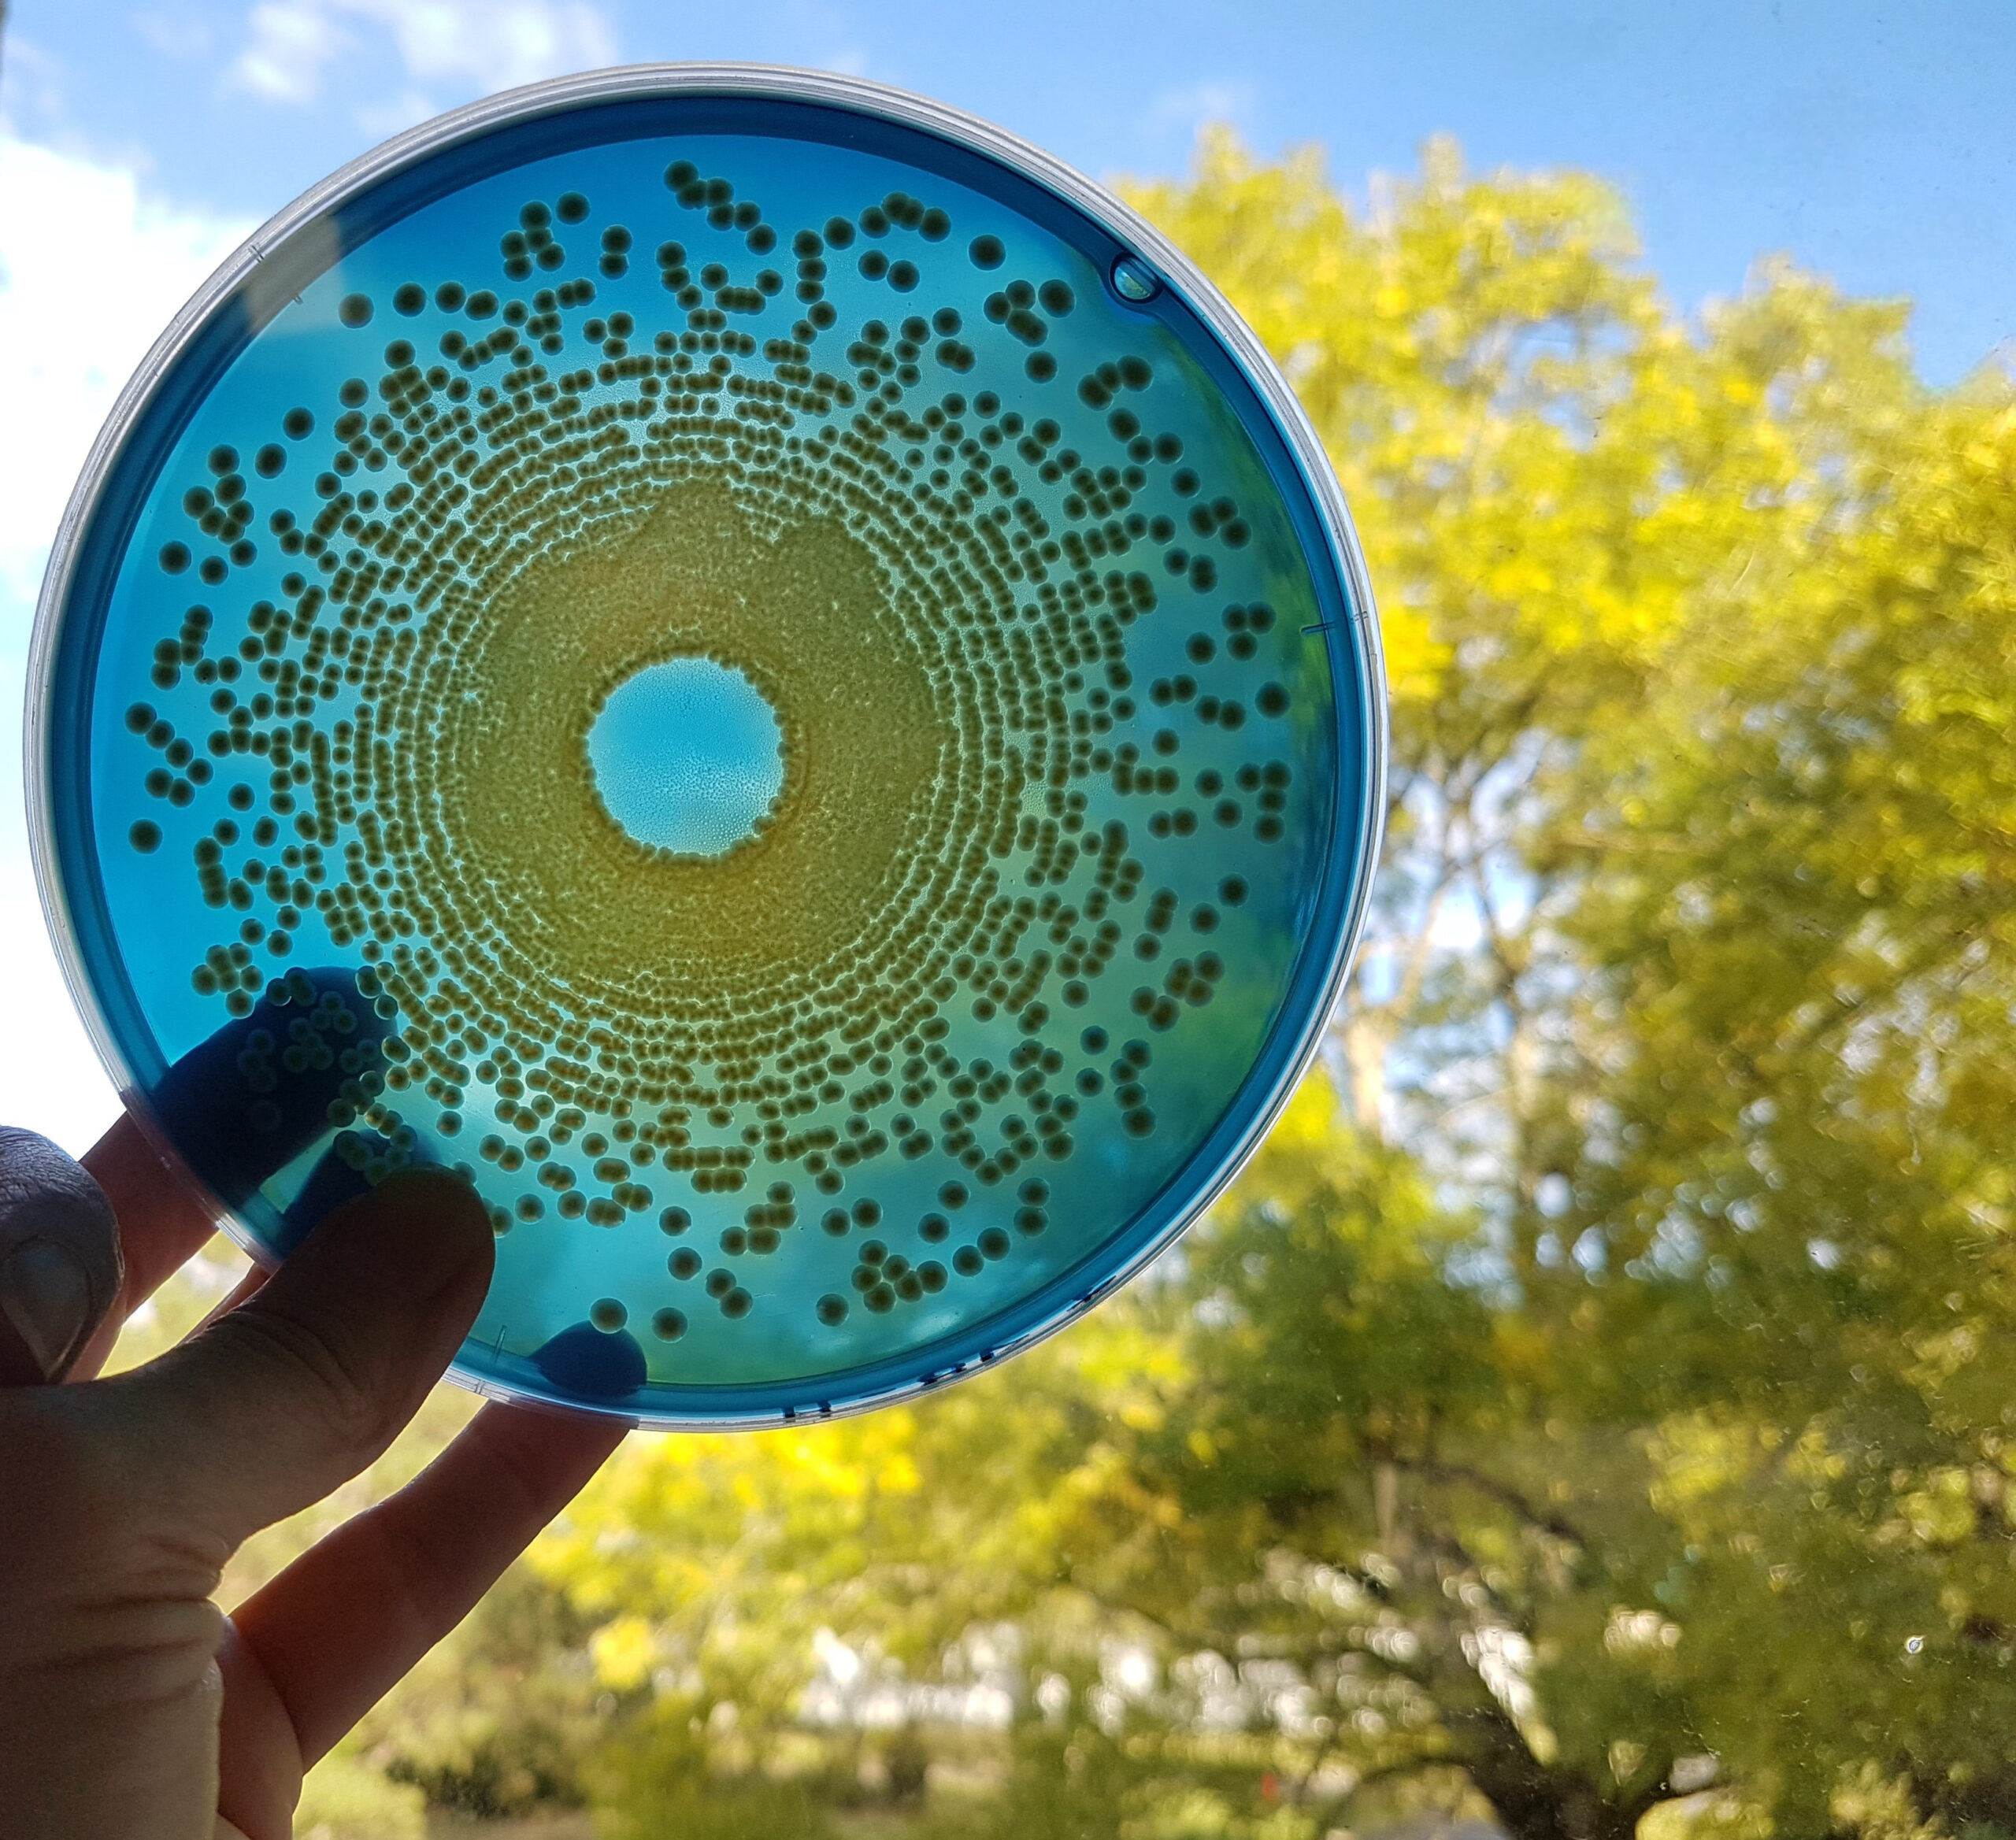
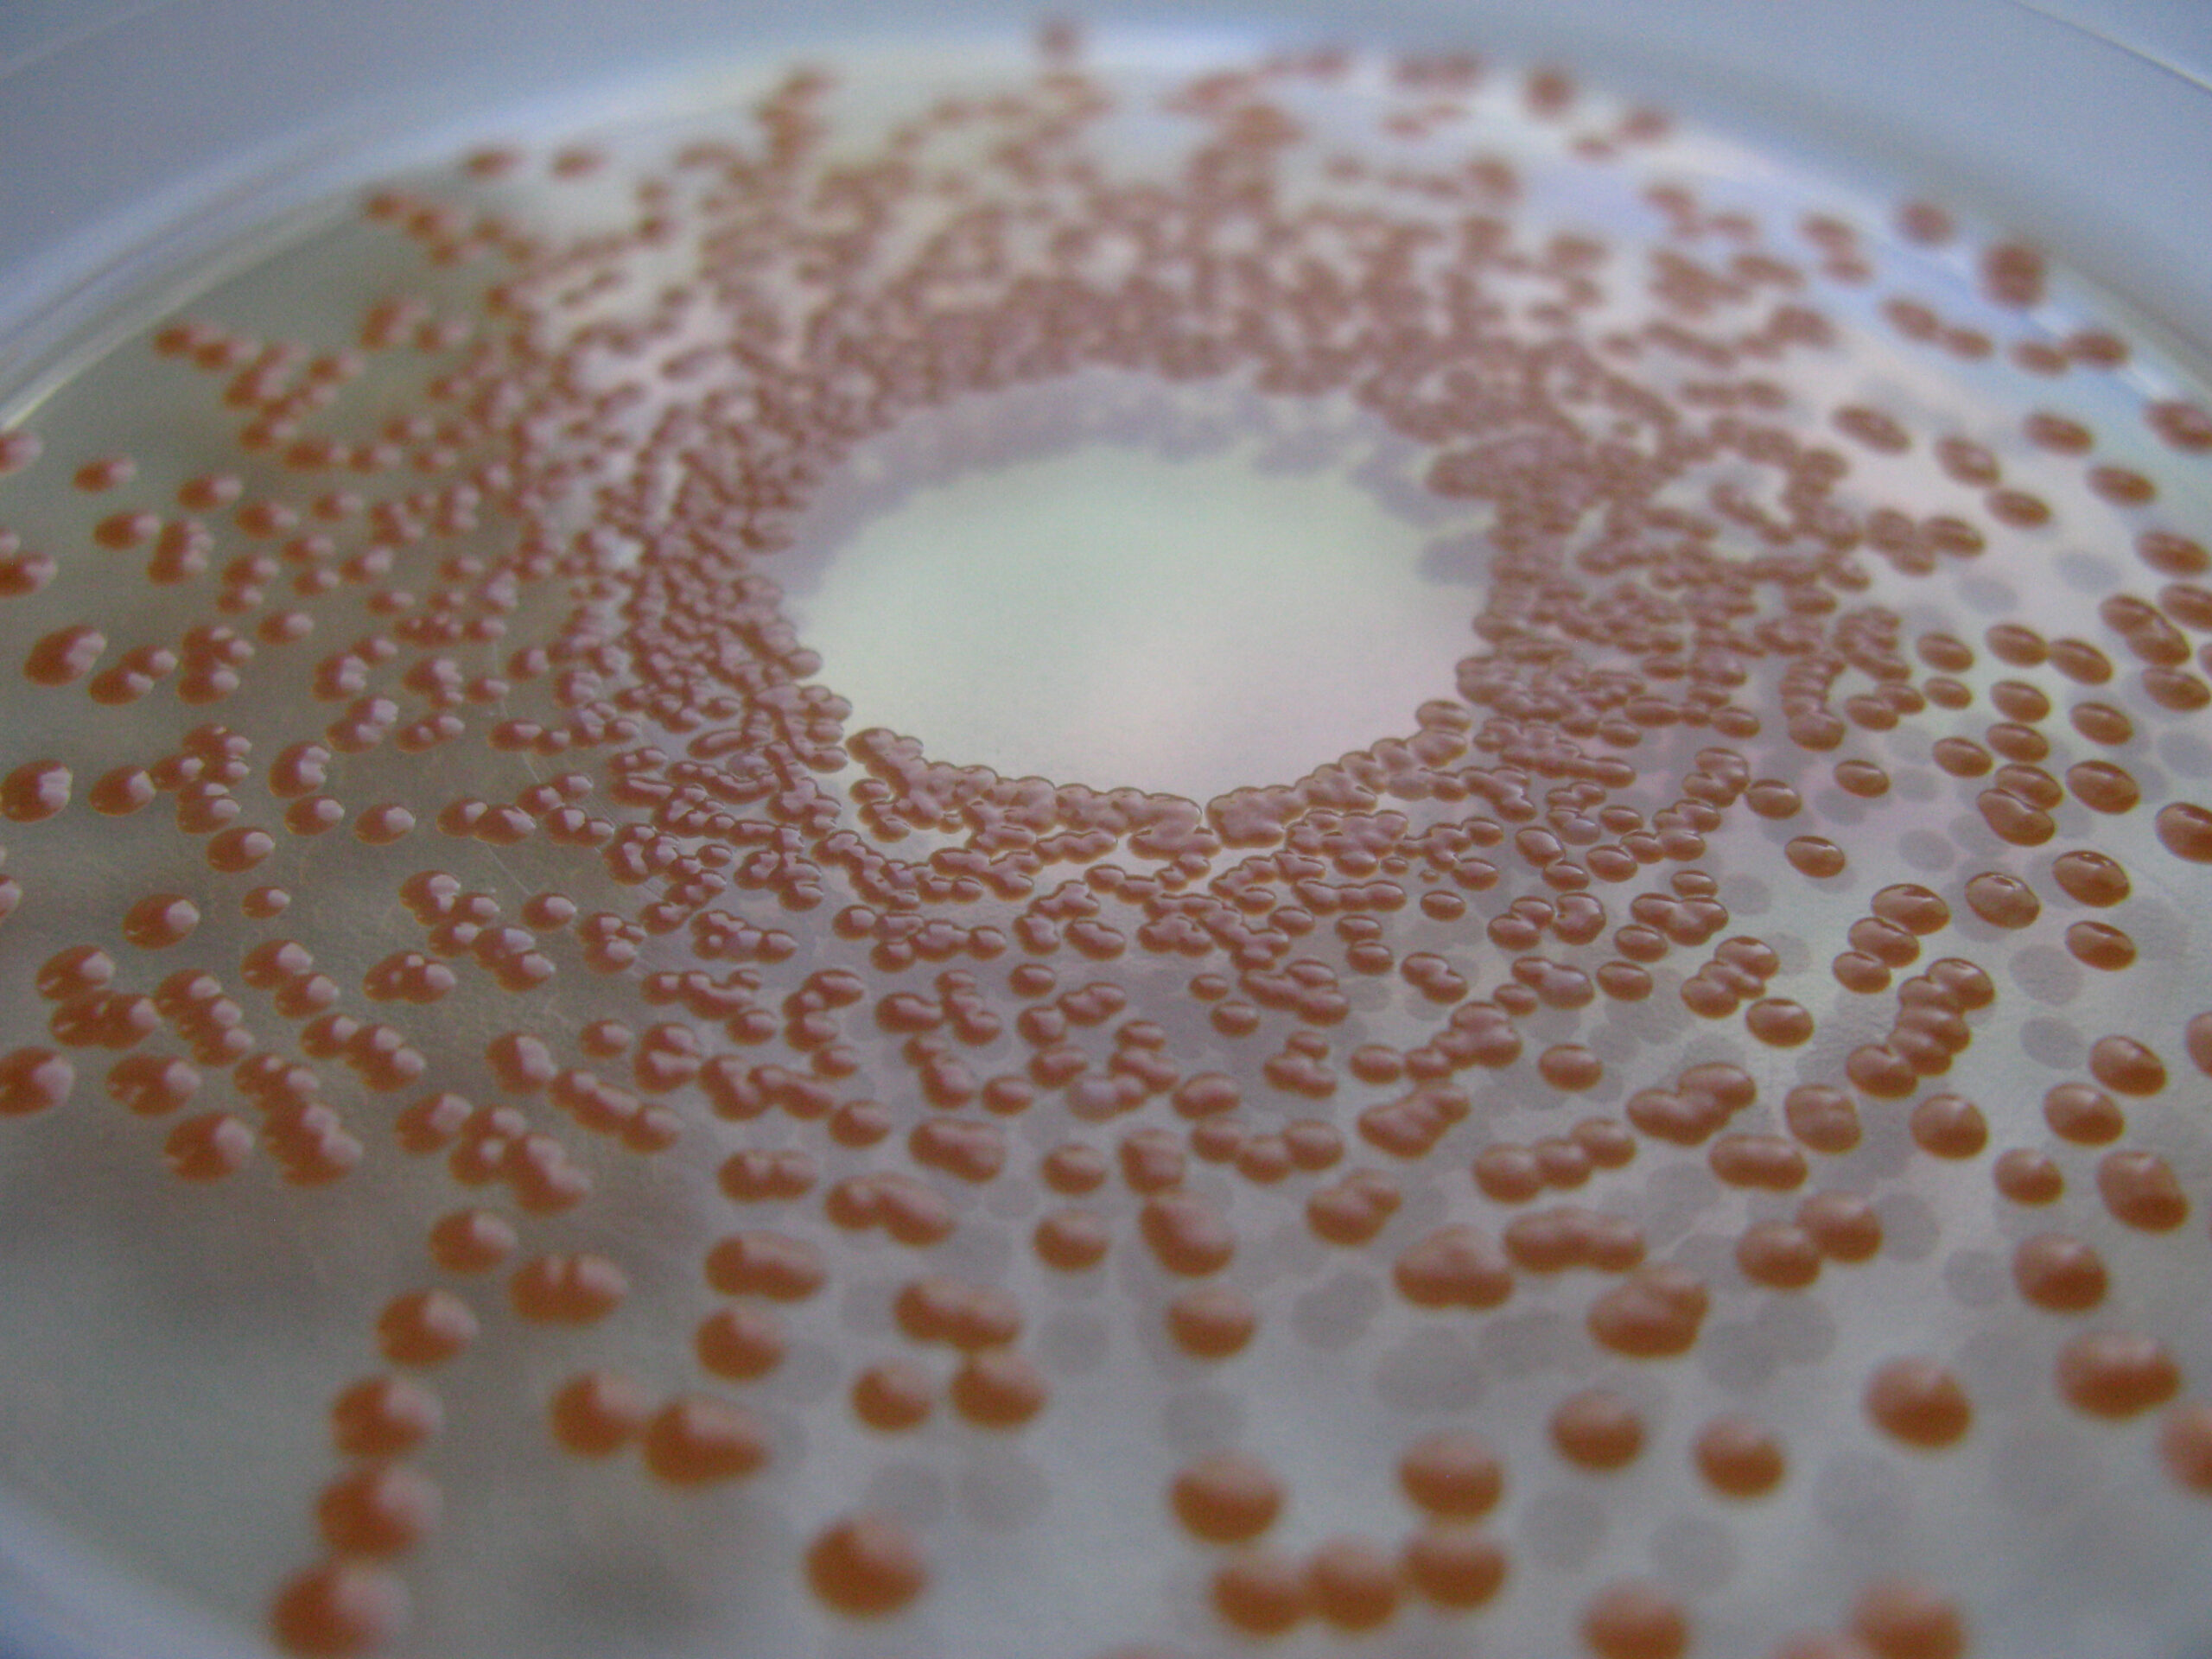

CIRM-BP Centre International de Ressources Microbiennes dédié aux Bactéries Pathogènes

Le CIRM-BP est un Centre de Ressources Biologiques (CRB) d’INRAE dédié à la conservation, la distribution et la valorisation de souches bactériennes. Il héberge des espèces pertinentes pour l’animal ou l’homme, dont une majorité est pathogène. Les souches proviennent des collections INRAE, de collectes ciblées et de collaborations académiques et privées. Le CIRM-BP exploite également la biodiversité de ces ressources pour la recherche, notamment en caractérisant le potentiel antibactérien de différents actifs dans le cadre de projets collaboratifs.

Liens utiles
- Site du CRB CIRM-BP dédié aux bactéries de l’animal et de l’homme :https://reseau-cirm.hub.inrae.fr/crb-collections-et-catalogues/cirm-bp
- Site web du réseau de CRB CIRM :https://reseau-cirm.hub.inrae.fr/
- CIRM dédié aux bactéries alimentaires :https://reseau-cirm.hub.inrae.fr/crb-collections-et-catalogues/cirm-bia
- CIRM dédié aux Champignons filamenteux :https://reseau-cirm.hub.inrae.fr/crb-collections-et-catalogues/cirm-cf
- CIRM dédié aux Bactéries associées aux plantes :https://reseau-cirm.hub.inrae.fr/crb-collections-et-catalogues/cirm-cfbp
- CIRM dédié aux Levures :https://reseau-cirm.hub.inrae.fr/crb-collections-et-catalogues/cirm-levures
- Site web de RARe, le Réseau français de Centres de Ressources Biologiques pour la recherche en biologie, agronomie et environnement :https://www.agrobrc-rare.org/
- Site web de MIRRI ERIC, l’Infrastructure de Recherche distribuée paneuropéenne pour la préservation, l’étude systématique, la mise à disposition et la valorisation des ressources et de la biodiversité microbienneshttps://www.mirri.org/
- Site web du réseau MuFoPAM. Ce réseau vise à regrouper différentes spécialités et compétences pour favoriser l’innovation thérapeutique autour de la multi-fonction des peptides antimicrobiens. Il s’intègre dans le défi actuel de lutte contre l’antibiorésistance autour du concept « One Health ».https://www.mufopam.fr/
- Site web de l’UMR ISP Infectiologie et Santé Publique :https://infectiologie-santepublique.val-de-loire.hub.inrae.fr/
- Site de la Plate-forme d’Infectiologie Expérimentale (PFIE). La PFIE est une référence en France mais aussi au niveau européen, dans la gestion des infections en confinement biologique de niveau de sécurité A1, A2, A3 et en isolateurs sur la plupart des animaux de rente, de laboratoire et des animaux de loisir et de la faune sauvage :https://pfie.val-de-loire.hub.inrae.fr/
- Site de PIXANIM, plateforme expérimentale et analytique qui permet l’exploration de l’anatomie, des structures et des fonctions des systèmes biologiques constituant l’animal :https://pixanim.val-de-loire.hub.inrae.fr
Pour nous citer:
Dans la partie « Matériels et Méthodes », la PFIE doit être citée comme une infrastructure réalisant des expérimentations validées par un comité d’éthique. Outre les détails mentionnant éventuellement le niveau de confinement et toutes autres informations concernant les conditions d’hébergement des animaux, la citation minimale à faire figurer, sera la suivante, en respectant le libellé relatif à la PFIE : “All experiments were conducted in accordance with the guidelines of the directive 2010/63/EU of the European Parliament and of the Council, in the facilities of the Plate-Forme d’Infectiologie Expérimentale: PFIE, UE-1277, INRAE, Centre Val de Loire, Nouzilly, France (doi: 10.15454/1.5572352821559333E12). All experimental procedures were approved by the Loire Valley ethical review board (CEEA VdL, committee number 19).”
Si vous souhaitez remercier la PFIE dans une publication, nous vous encourageons à citer tous les intervenants de votre protocole. Le format de citation des personnels concernés (UE-1277 PFIE) à utiliser est le suivant : “The authors are grateful to the members of the scientific and animal staff of the Plate-Forme d’Infectiologie Expérimentale: PFIE, UE-1277, INRAE, Centre Val de Loire, Nouzilly, France (doi: 10.15454/1.5572352821559333E12), especially to the study managers*/animal technicians in charge of this study: AAA, BBB and CCC…”. Le chargé d’études (study manager) sera remercié/e, s’il/elle n’est pas associé/e comme co-auteur de la publication.
Prestations
Les utilisateurs doivent mentionner le CIRM-BP dans les publications (partie Matériels & méthodes et/ou remerciements), en le nommant et en faisant figurer son DOI :
- En anglais : CIRM-BP. (2021). International Centre of Microbial Resource (CIRM) dedicated to pathogenic bacteria for animal or human. INRAE. https://doi.org/10.15454/MHZW-8B32
- En français : CIRM-BP. (2021). Centre International de Ressources Microbiennes dédié aux Bactéries Pathogènes de l’animal ou de l’homme, INRAE https://doi.org/10.15454/mhzw-8b32
Dans le cas d’une forte implication du CRB et si les résultats produits sont essentiels à l’article ou à la communication, les personnels de la plate-forme ayant mené les expériences doivent faire partie des co-auteurs de la publication avec l’affiliation suivante :
INRAE, Université de Tours, ISP, 37380, Nouzilly, France
Compétences
Le CRB CIRM-BP, certifié ISO 9001 depuis 2008, propose les différents produits et services suivant :
- Fourniture de souches de bactéries pathogènes.
- Fournitures d’ADN génomiques.
- Conservation de souches pour diffusion immédiate ou différée à la communauté scientifique.
A faire en parallèle de vos publications mentionnant ces ressources ou de vos projets scientifiques les utilisant, ou dès lors que vous souhaitez garantir la pérennité, la visibilité et l’accessibilité à vos souches.
- Conservation en dépôt fermé : dépôt confidentiel et privé. L’accès au matériel microbiologique et aux données associées doit être autorisé par le déposant.
- Isolement et purification de souches.
- Identification d’isolats microbiens jusqu’au niveau du genre ou de l’espèce, par méthodes de bactériologie classique (phénotype et tests biochimiques), séquençage de marqueurs moléculaires et/ou spectrométrie MALDI-TOF.
- Génotypage de souches bactériennes.
- Lyophilisation de cultures de souches microbiennes pour la conservation à long terme.
- Test de la résistance de souches à différents antibiotiques (Antibiogramme, Concentration Minimale Inhibitrice)
- Caractérisation du spectre d’action antibactérienne de différentes molécules ou extraits, qu’ils soient d’origine naturelle (végétale, animale, marine…) ou issus de synthèse chimique.
Le CIRM-BP étudie par ailleurs toutes les demandes de services personnalisés ou de collaboration de recherche afin de répondre au mieux aux besoins de ses utilisateurs.
Bactériologie classique
Biologie moléculaire
Identification bactérienne par spectrométrie de masse MALDI-TOF
Equipement
Une collection de plus de 3300 souches bactériennes pour des applications médicales ou vétérinaires et la recherche.
Laboratoires L2 et L3 permettant de gérer les collections de bactéries pathogènes de classes de risque 2 et 3 dans le respect des règles de sécurité en vigueur.
Postes de sécurité microbiologique de type II
Automate de pipetage,
Analyseur-incubateur de microplaques Bioscreen C,
Dilueur et ensemenceur automatique de boîtes de Pétri,
Compteur automatique de colonies et lecteur de zones d’inhibition,
Inoculateur multipoint,
Loupe avec possibilité de transillumination oblique pour l’observation des boîtes.
Accès au spectromètre de masse MALDI-TOF de la plateforme PIXANIM pour l’identification bactérienne
Personnels
Claire Darrigo, Technicienne de Recherche
Emilie Chambellon, Assistante Ingénieur
Emmanuelle Helloin, Ingénieure de Recherche, Responsable du CIRM-BP
Travaux & Collaborations
Le CIRM-BP est ouvert à la communauté scientifique, académique ou privée. Il participe régulièrement à des projets de recherche d’envergure régionale, nationale et européenne. Implanté sur le centre INRAE Val de Loire au sein de l’unité mixte de recherche Infectiologie et Santé Publique (UMR ISP 1282) qui associe INRAE et l’Université de Tours, le CIRM-BP bénéficie d’un environnement scientifique riche en expertises. Ces expertises couvrent la connaissance d’agents pathogènes tels que Brucella, Escherichia coli, Mycobacterium, Salmonella, Staphylococcus et Streptococcus, ainsi que les mécanismes des infections et de leur contrôle. Le CIRM-BP collabore également avec la Plate-Forme d’Infectiologie Expérimentale (PFIE) voisine. Cette dernière constitue le plus grand dispositif expérimental français en infectiologie. Elle offre des possibilités d’expérimentation en système confiné (A2 et A3) sur la plupart des animaux de rente ou de laboratoire.
Publications
Pubmed depuis 2012